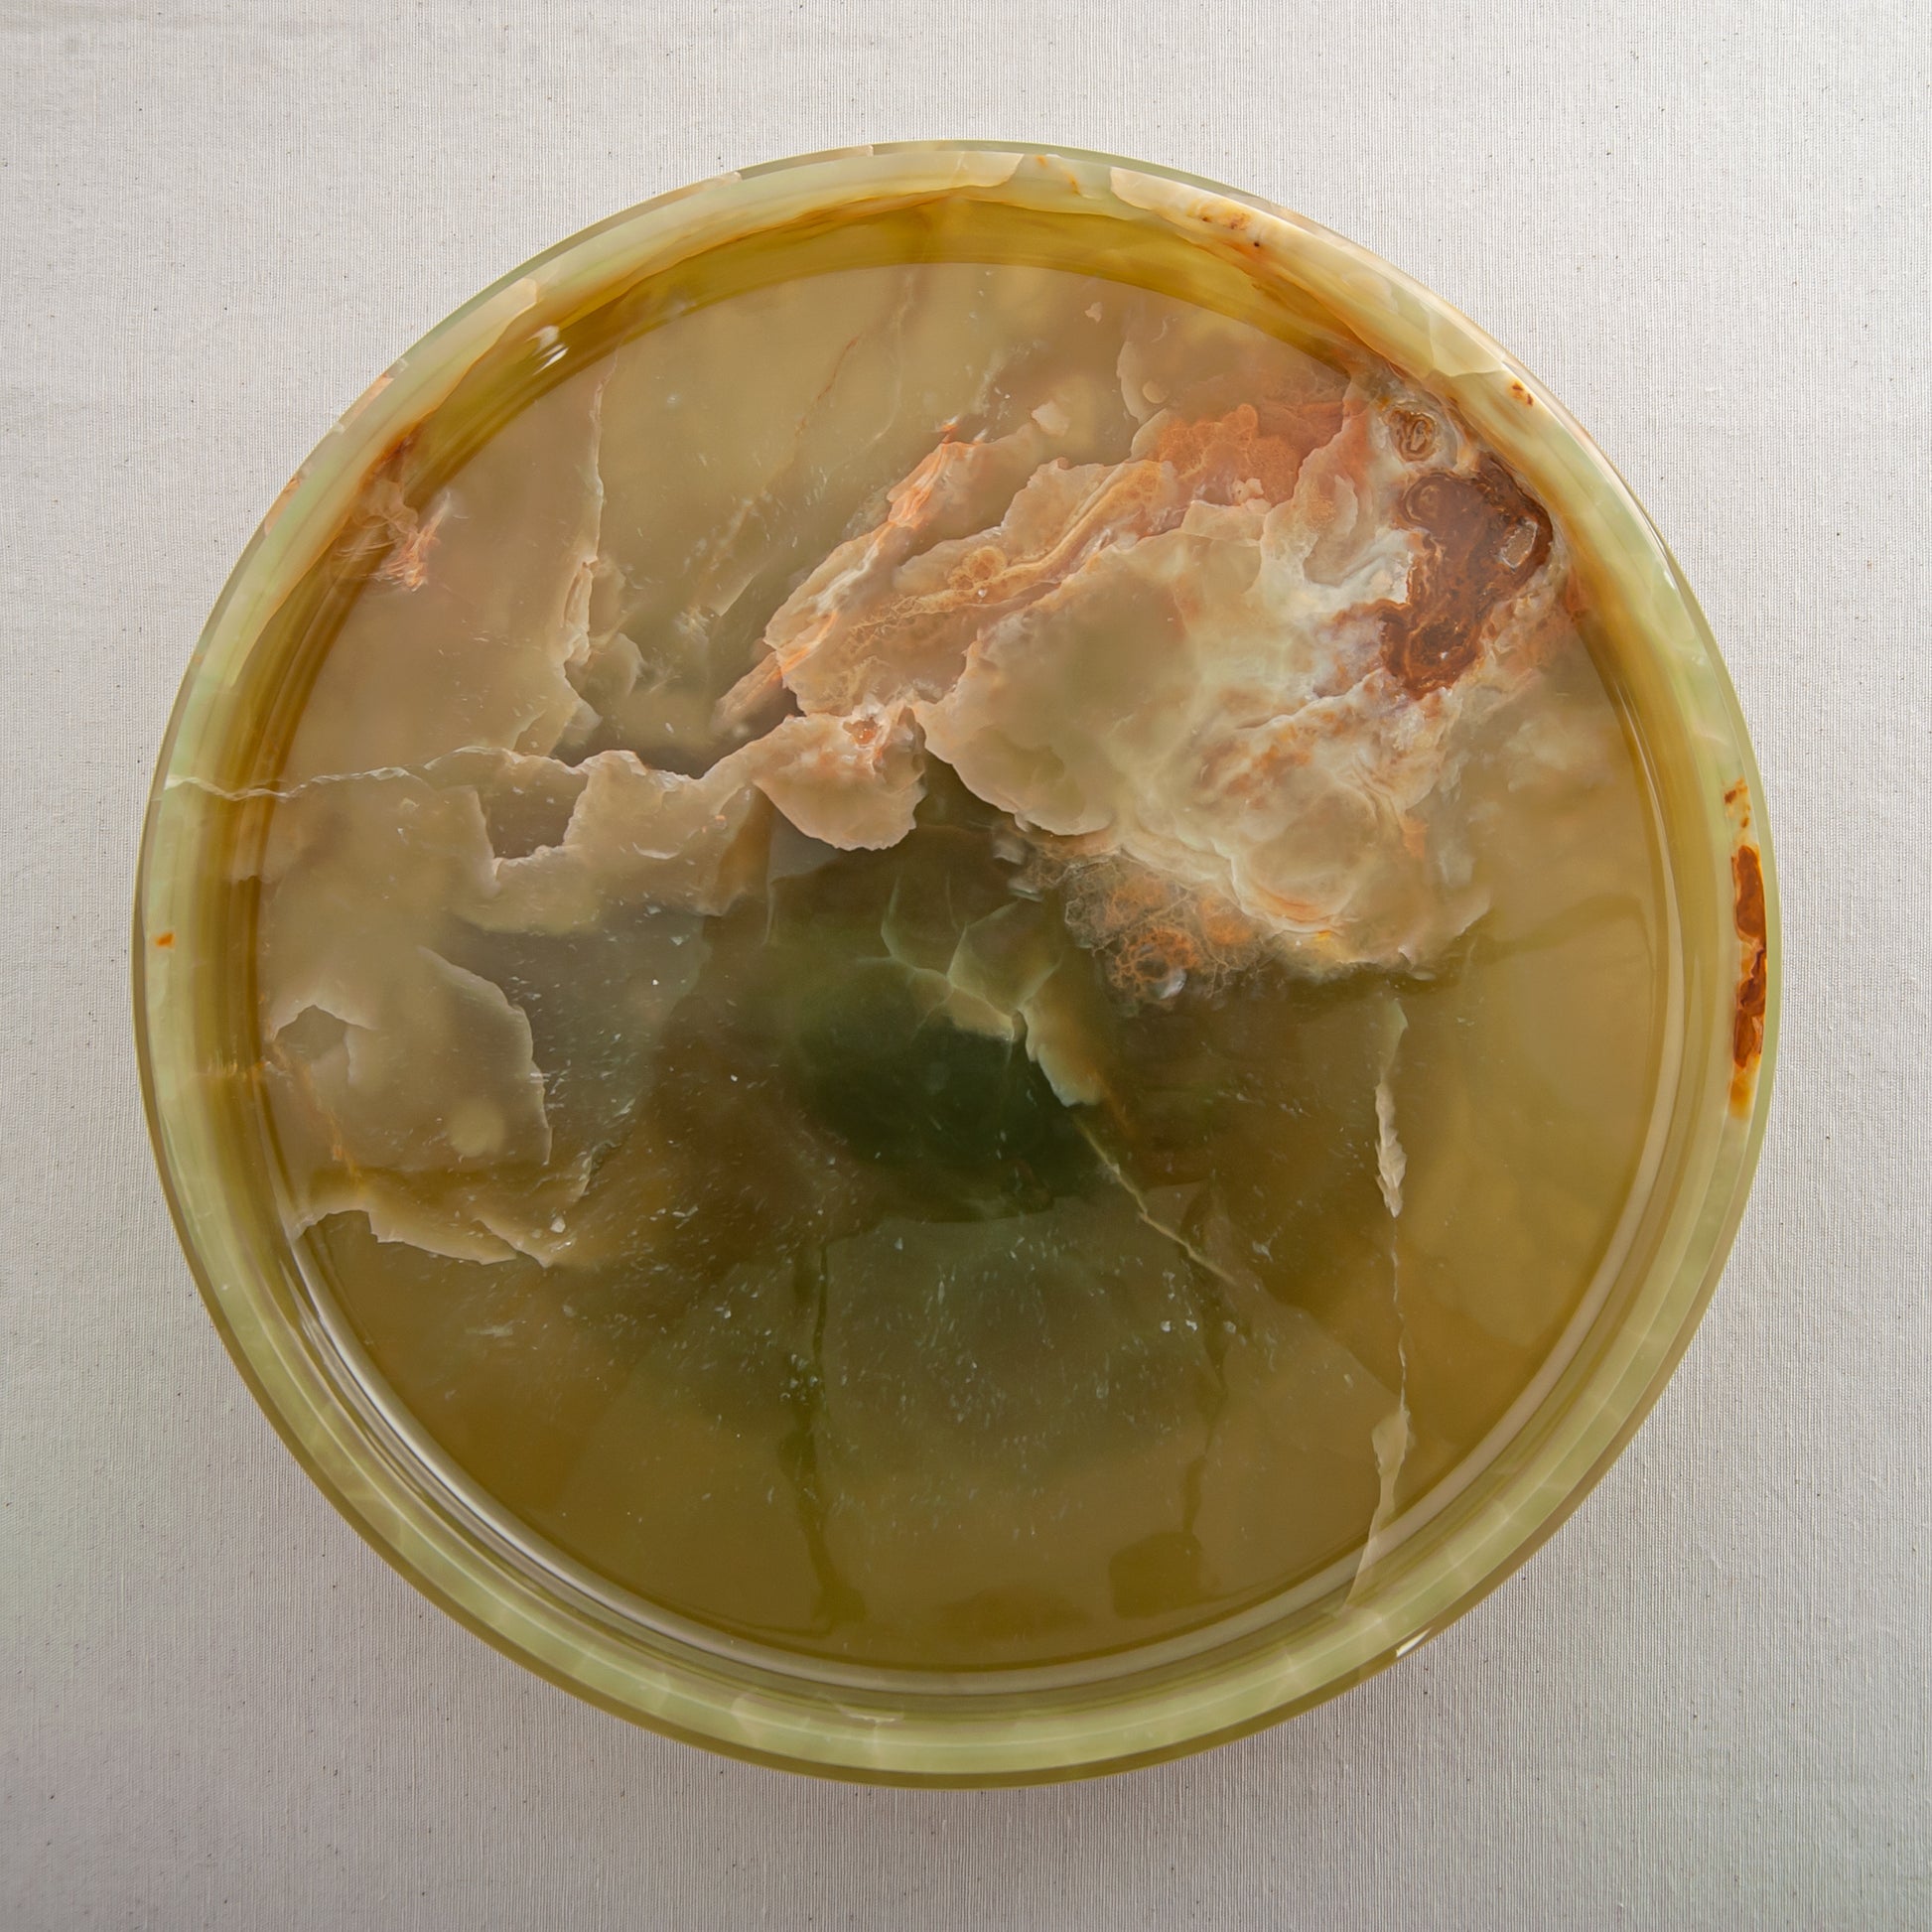

This piece already found its home
As most of our creations are one of a kind, they exist only once.
Once collected, they will not be restocked.
Verdelle Cake Stand
Verdelle Cake Stand
Onyx
The Verdelle Cake Stand is a refined celebration of natural stone and elevated form. Carved from translucent green onyx, its surface reveals soft layers of moss, jade, and warm mineral veining, creating a gentle interplay of color and depth.
Resting on a subtly sculpted pedestal, the stand feels both grounded and light. The polished stone captures and diffuses light, allowing the natural patterns to glow with a quiet luminosity. Each Verdelle Cake Stand is unique, shaped by the organic character of the onyx and finished by hand.
Designed to present cakes, pastries, or cherished objects, the Verdelle Cake Stand brings a sense of calm elegance to any setting, a timeless piece where function meets sculptural beauty.
Share this product

Nature meets handcraftmanship
Each piece is shaped by skilled hands and guided by the natural character of the stone. In our atelier, exceptional stones are carefully selected and transformed through craftsmanship, allowing their unique veins, colors, and textures to emerge.
The result is a singular creation where nature and artistry meet.

Get inspired









Experience Natural Stone in Our Berlin Store
Located in the heart of Berlin, our store is a place to experience rare stones, refined craftsmanship, and the timeless beauty of natural materials.

Free & fast delivery
Express Delivery & Free Shipping Options

Customer support
Support via WhatsApp & Email

Easy return
Exchange or return items within 14 days

Safe payment methods
PayPal, Klarna, Apple Pay, Google Pay and all credit cards